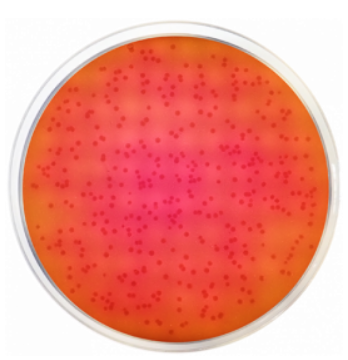
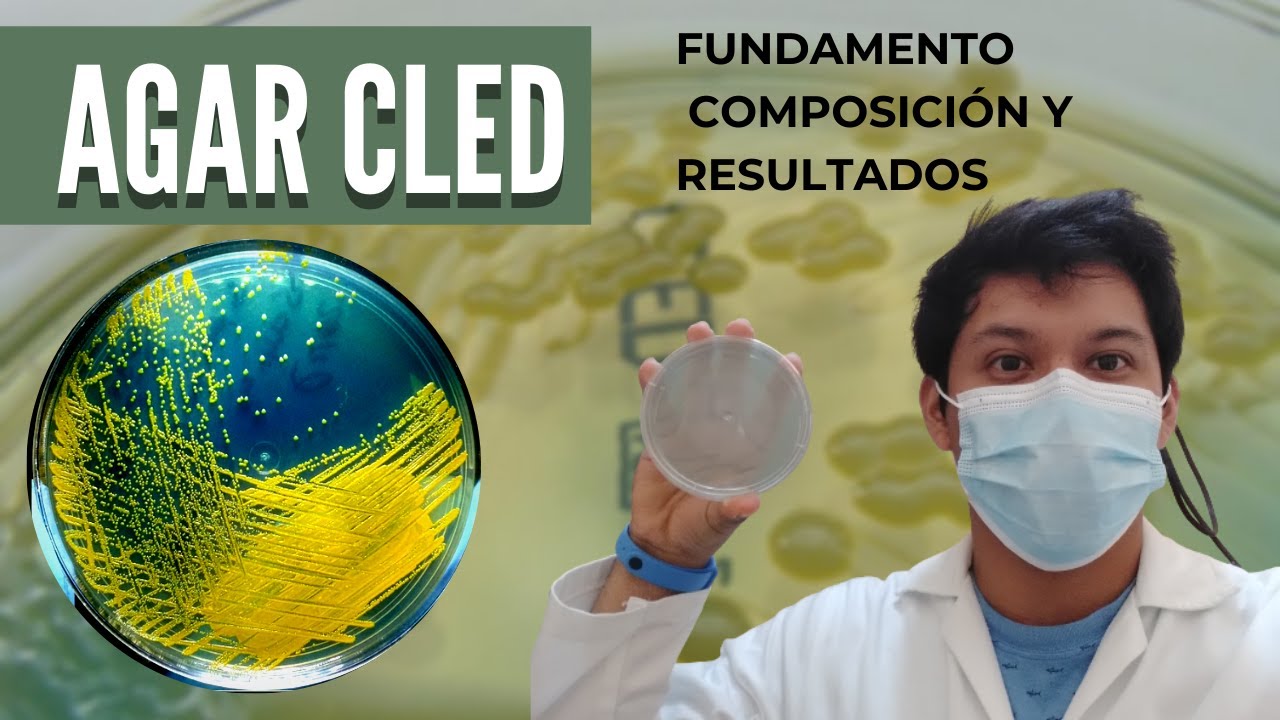
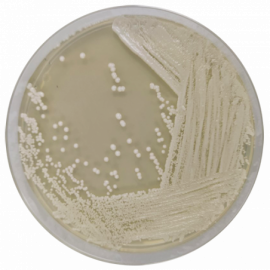
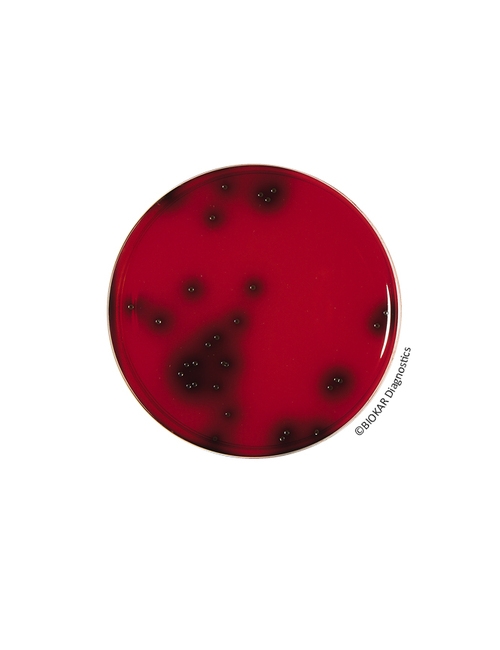
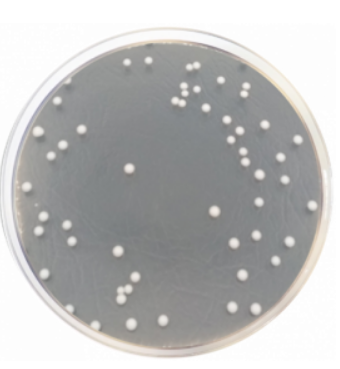
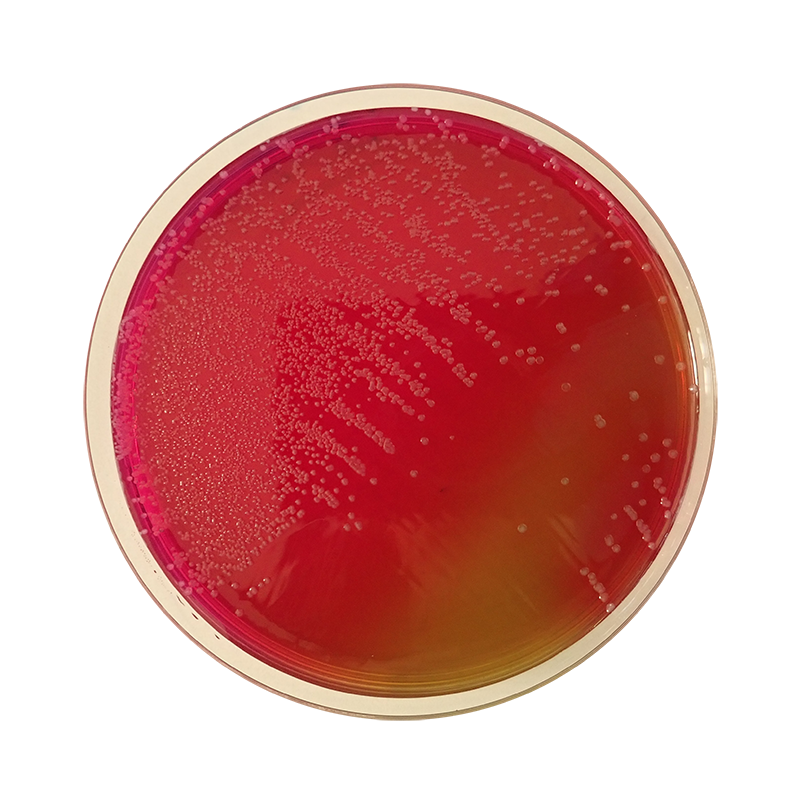

L агар
L агар 143 фотографий
Дрянной герцог не знает границ 28 глава
Собирать пазлы детям 7 лет
Тв мебель современная
119 автобус краснодар расписание
Организационный или технологический характер
Сусальный переулок 5 стр 17
Политологи 1 канал
Резиновая клюшка
Электронная панель на ниву
Оплата штрафа роспотребнадзора